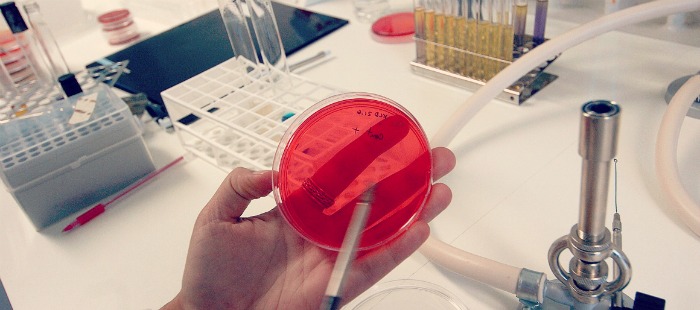
producao_cientifica_capa

Curso de Química participa da Semana Nacional de Ciência e Tecnologia
Terça-feira, 13 de Outubro de 2015 às 15h29Na Semana Nacional de Ciência e Tecnologia, o curso de Química, realiza o evento: “Entrevista como o profissional” tratando o tema “ A importância da Produção Científica na formação acadêmica”. O evento será realizado no dia 14.10, das 10h às 11h40, na Unidade 11 – sala 11111.
O convidado especial será o Dr. Robério Fernandes Alves, vice-presidente da Associação Brasileira de Química – ABQ. O objetivo é discutir sobre o impacto e a experiência da produção científica na vida do estudante de Ensino Superior.
Inscrições gratuitas na Coordenação de Química, Unidade 11 – sala 11116 ou através do 3212-5062.